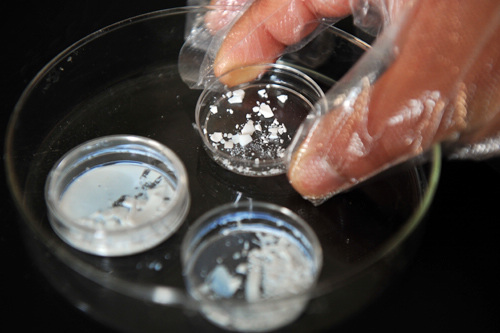

|
|
|
NANO BONE: The chemistry department of Zhejiang University has developed a nano material simulative bone, which is closer to natural bones in strength and viscosity. If put into use, it will help cure bone injuries (WANG DINGCHANG) |
China is one of the first few countries to have started research on nanoscience and technology and Bai has been an important witness and participant in the whole undertaking. After getting his doctoral degree from the CAS, Bai became a post-doctoral researcher at the California Institute of Technology in 1985, where he became the first Chinese researcher in the Scanning Tunneling Microscope (STM) field.
STM is vital for the development of nanoscience and technology, and serves as the "eyes" and "hands" for materials science. German physicist Gerd Binnig and Swiss physicist Heinrich Rohrer won the Nobel Prize for their development of the STM in 1986, one year earlier before Bai returned to his motherland and started nano research in China.
Bai and his colleagues invented China's first computer-controlled STM on April 12, 1988. From then on they were not satisfied simply to observe atoms but became determined to reconstruct them. Bai's STM team eventually developed into an international lab.
The Central Government has offered considerable support to nanotechnology research. In order to allow relevant scientists to communicate with each other, the government established a national network connecting all large research centers for nanoscience and technology.
China possesses almost all the rare mineral substances and biological resources needed for high-level nanotechnology research. The country's consumer market also offers a huge incentive for the development of products that use nanotechnology.
In China, nano-related technologies are already being put to daily use; green nano printing technology, quick and low-cost AIDS tests and the Lithium-ion battery are applications that demonstrate the field's potential.
The Institute of Chemistry under the CAS has created a new nano material for printing. Printing with this material costs less, pollutes less and printing plates can be recycled.
"The green nano plate making and printing technology is likely to catalyze a revolution in the printing industry," said Bai.
Traditional printing uses a number of chemicals and consumes a lot of energy, but the new nanotech printing method eliminates chemical treatment steps by allowing publishers to directly print images onto the plate.
The team led by Song Yanlin, a researcher at CAS's Institute of Chemistry, has achieved huge breakthroughs in applying nanotechnology to improve printing accuracy and increase the life of plates.
Song secured 24 million yuan ($3.75 million) as the initial capital for his plant established in 2009. A production base will soon be put into operation. The plant will annually produce printing plates of 6 million square meters and other printing materials using nanotechnology, with technical support from CAS and Lenovo.
Diagnosing diseases
Scientists are also using nanotechnology to diagnose and cure diseases.
A magnetic nano microsphere with improved capacity, or nano prober, has been invented and made by the Research Institute of Micro/Nano Science and Technology of the Shanghai Jiao Tong University. The device can be used in biomedicine to test for myocardial infarction, hepatitis and AIDS. It can also be used for food safety tests—to determine the amount of pesticide in fruits and vegetables and illegal additives in food.
The team with the university made a breakthrough in terms of magnetic nanoparticles the microsphere contains. The amount of magnetic nanoparticles was increased from below 35 percent in the past 30 years to more than 70 percent at present, which has significantly shortened the test time.
In detecting AIDs or other major communicable diseases, the magnetic nano microsphere is a powerful diagnostic tool 10 to 100 times more sensitive than existing tests using optical signals.
The improved sensitivity allows the device to save lives. For instance, the death rate for acute myocardial infarction is very high and the key to rescue lives lies with diagnosing it as early as possible. While an ordinary examination takes about 40 minutes, magnetic nano microspheres can reduces detection time to about 20 minutes. They can also sensitively detect latent viruses that traditional examination technologies may not identify.
While saving test time and lives, the magnetic nano microsphere, smaller, more sensitive and adjustable for various situations, also remarkably reduces the medical cost for patients.
In addition, researchers from Yunnan University and Jilin University have developed the nanocrystalline test paper for AIDS and hepatitis B detection. |